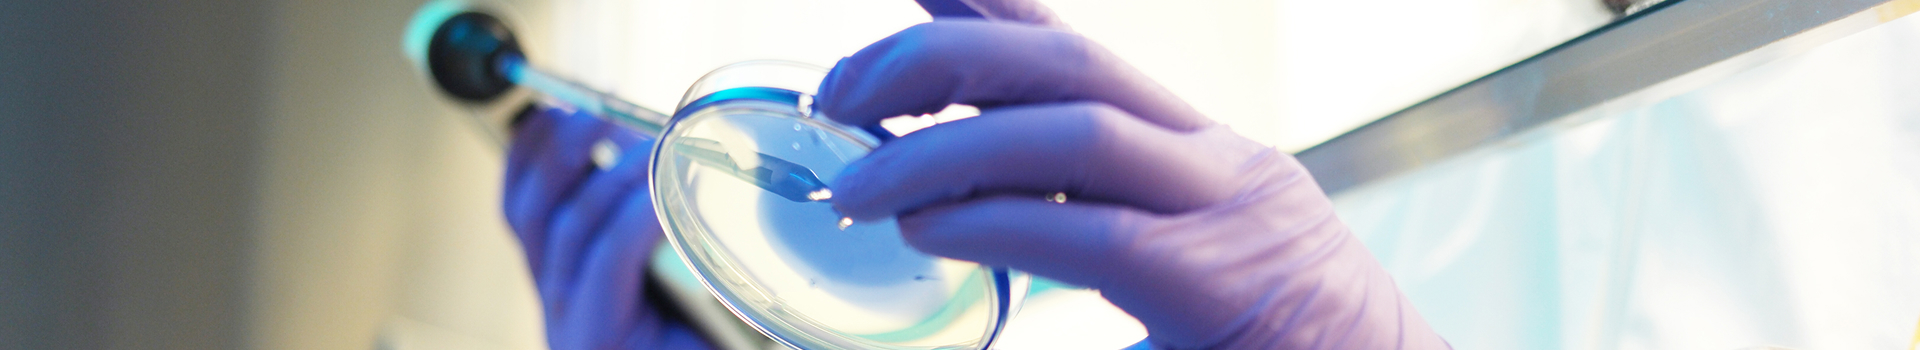

Research Operations
Research Operations Core
Our research advances donor-based nationwide surveillance of infectious disease dynamics and vaccine responses, integrating study and biorepository operations, multiplex and ultrasensitive assays to study SARS-CoV-2, arboviruses, HIV, and emerging pathogens of public health concern with laboratory analytics with epidemiologic modeling to define correlates of immunity, characterize viral persistence and inform public health and transfusion safety policies and contributes to pandemic preparedness.
The ROC under Dr Stone’s direction designs, executes, and standardizes end-to-end study operations—from protocol development and biospecimen collection to cell isolations, study-specific processing, testing, data linkage, and long-term storage through the VRI Biorepository. This infrastructure supports multicenter clinical and observational studies, enabling high-quality, reproducible data generation across diverse research programs.

Mars Stone, Ph.D.
Senior Director, Core Laboratories
Mars Stone, Ph.D., is Senior Director of Core Laboratories and Director of the Research Operations Core at Vitalant Research Institute (VRI). Dr. Stone joined the Research Institute after completing graduate and post-doctoral work at the University of California, Davis, investigating rhesus macaque models of HIV vaccines and in vivo viral evolution. Current research interests revolve around emerging infectious pathogens and public health response, transfusion-transmitted viruses, blood screening and diagnostics assays and transfusion efficacy. The Stone lab leads a range of multicenter clinical and translational studies in these areas.
Dr. Stone’s research focuses on donor-based serosurveillance for pathogens of public-health concern (e.g., SARS-CoV-2, influenza, RSV), transfusion-transmitted infection risk, vaccine effectiveness and correlates of protection, and ultrasensitive virologic assays—including single-copy HIV RNA—for pathogenesis and cure-directed studies. She collaborates widely with internal VRI investigators, the Centers for Disease Control and Prevention, academic partners, and industry to generate actionable evidence that informs blood safety, infectious-disease surveillance, and preparedness. Dr Stone has published over 200 papers.
Publications
Core Team Members
Research Operations Core Services
The ROC under Dr Stone’s direction designs, executes, and standardizes end-to-end study operations—from development and validation of screening and diagnostic assays, protocol development and biospecimen collection to cell isolations, study-specific processing, testing, data linkage, and long-term storage through the VRI Biorepository. This infrastructure supports multicenter clinical and observational studies, enabling high-quality, reproducible data generation across diverse research programs.
Cell isolations & study-specific processing
- PBMC isolation: Ficoll/CPT from whole blood or leukapheresis with defined time/temperature windows and QC.
- Cryopreservation & recovery: Controlled-rate freezing, LN₂ vapor storage, post-thaw viability/yield checks.
- Subset enrichment: Magnetic selection (e.g., CD4⁺, CD8⁺, CD14⁺, B cells) with pre/post purity assessment; optional aliquoting for multi-omics.
- Study-specific workflows: Plasma/serum separation, buffy coat/granulocyte preps, whole-blood RNA stabilization (PAXgene/Tempus), live-cell steps (e.g., stimulation, intracellular staining)
Biospecimen lifecycle oversight
- On-site collection oversight
- Phlebotomy and processing SOPs, order-of-draw, pre-analytical variables, deviation capture.
- Central receipt, accessioning, and triage
- Chain-of-custody, condition checks, reconciliation to manifests, triage to testing vs. storage.
Study planning & start-up
- Operational protocol development
- Convert study aims into SOPs, manuals, kit lists, processing/ship windows, hold times, and test menus.
- Define inclusion/exclusion and visit schedules from a biospecimen/assay standpoint.
- Feasibility & pilot runs
- Pre-launch pilots to confirm draw volumes, tube types, stability, and assay performance.
- Site selection & activation
- Qualify sites for collection capability, cold-chain access, and data capture.
- Deliver initiation trainings; maintain version-controlled documents.
Kit manufacturing & logistics
- Collection kit build
- Barcoded tubes, shippers, RTC/2–8 °C/−20 °C/−80 °C materials, IFUs, return labels.
- Cold-chain shipping coordination
- Supply forecasting & resupply
- Rolling forecasts and supply tied to enrollment
Assay development & validation
- Fit-for-purpose validation
- Analytical sensitivity/specificity, linearity, precision, matrix effects studies.
- Proficiency & lot-to-lot controls
- In-house proficiency panels; external QC programs
- Documentation
- Validation plans/reports, change controls, and versioned SOPs aligned to sponsor/regulatory expectations.
Central laboratory testing management (VRI)
- Serology testing and panels
- NAT / molecular detection and sequencing
- Ultrasensitive assays
- Single-copy HIV RNA (replicate-based platforms and validated manual methods) for residual viremia; p24 where suited.
- Bridging & method transfer
- Cross-platform comparisons, dilution schemes, LoD/LoQ verification to support multi-site harmonization.








